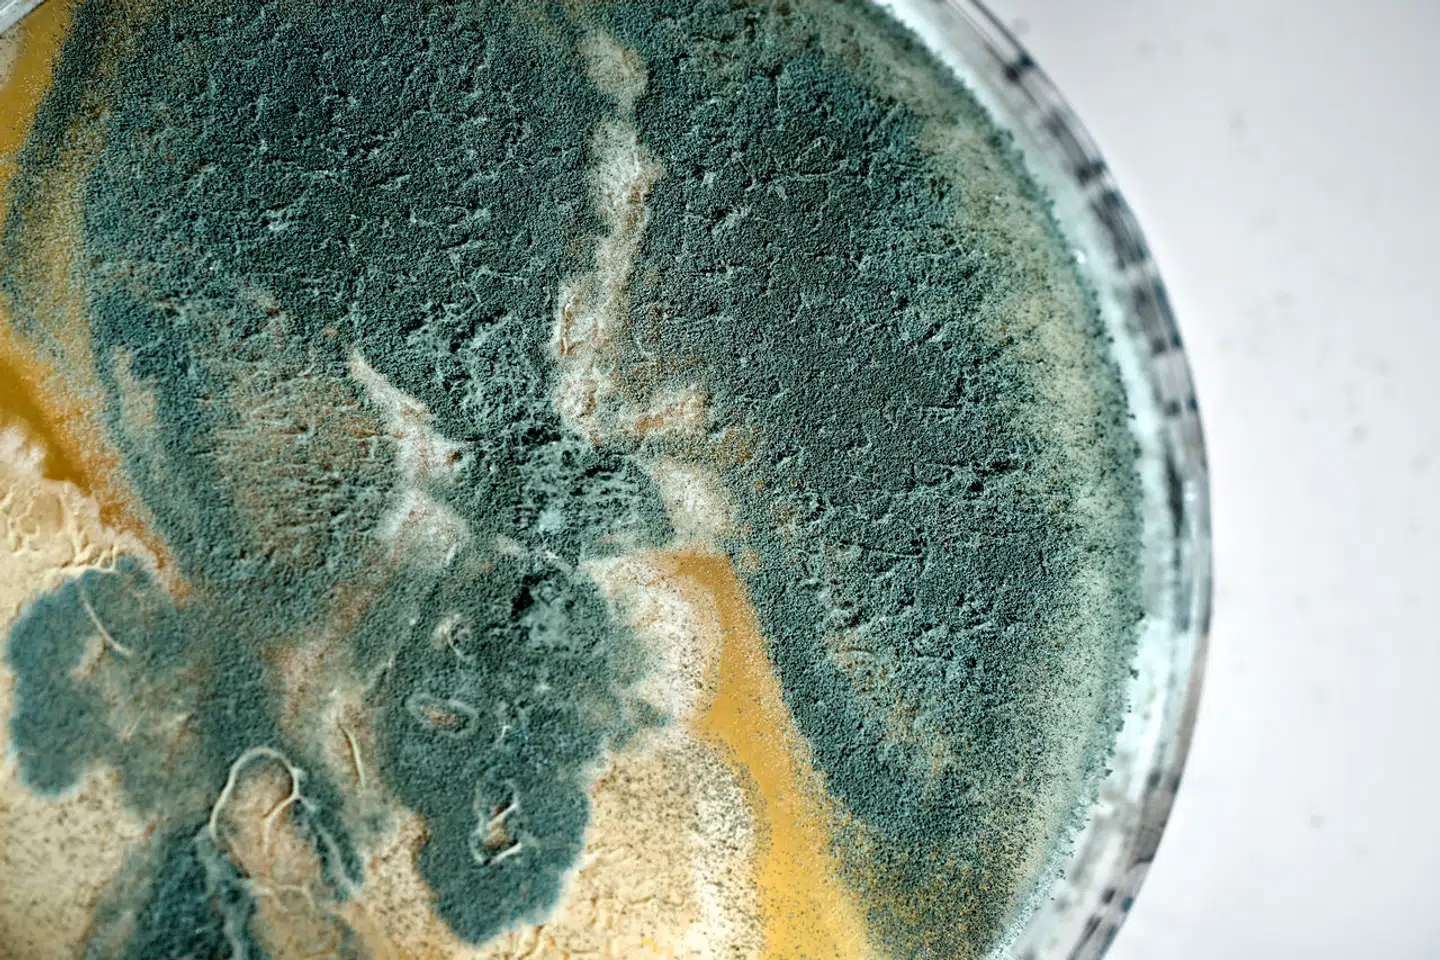
Ud over en Aspergillus flavus, som i flere tilfælde har inficeret patienter, er der også fundet resistente partikler fra svampen Aspergillus fumigatus på blandt andet børnekræftafdelingen.

Adskillige forskere og ledende medarbejdere ved Rigshospitalet og Statens Serum Institut har i mere end et år haft detaljeret kendskab til, at en række stuer og afdelinger på Rigshospitalet igen og igen er blevet hårdt ramt af skimmelsvamp, og at svampene i flere tilfælde er blevet overført til patienter.
Det fremgår af en lang række e-mail fra 2022 og 2023, som Berlingskes har fået aktindsigt i.
Den omfattende korrespondance viser, at især én type skimmelsvamp har plaget Rigshospitalet, blandt andet på afdelingen for kræftsyge børn. Og at de kontinuerlige fund har udløst dyb bekymring blandt de ansatte.
Situationen har gennem 2023 været så alvorlig, at forskere og ansatte flere gange er gået til Rigshospitalets ledelse, ligesom man har diskuteret, at de skimmelramte patienter bør kunne få erstatning.
Indholdet af disse e-mail mellem ansatte ved Rigshospitalet og Statens Serum Institut står i skarp kontrast til de offentlige udtalelser, som Rigshospitalet har givet til patienter og offentlighed som reaktion på Berlingskes dækning den seneste måned.
I interview og skriftlige svar har Rigshospitalet konsekvent forsøgt at dysse sagens alvor ned: Der er fuld styr på skimmelsvampen; de berørte områder bliver omgående »forseglet, renoveret og saneret«.
Eller som Rigshospitalets vicedirektør, Jannick Brennum, formulerede det 30. januar i P1 Morgen:
»Der er ingen grund til at være bekymret.«
Konstitueret vicedirektør Helen Bernt Andersen udlagde det på denne måde i P1 Morgen 8. januar:
»Jeg er selvfølgelig rigtig ked af, at artiklerne kan have været med til at bekymre patienter og pårørende. Det er der ingen grund til.«
Måske vigtigst:
Rigshospitalet har over for Berlingske afvist, at hospitalet burde have orienteret patienter eller pårørende om, at patienterne under indlæggelsen blev påført svampeinfektioner fra hospitalets sengestuer og rum.

Eksperter har kritiseret, at patienter og pårørende er blevet holdt i uvished. For det forhindrer de skimmelramte patienter i at søge om erstatning, når de aldrig har fået at vide, hvorfor de fik svampeinfektioner.
Rigshospitalet har henvist til, at hospitalet ikke har oplysningspligt om forskningsresultater.
»Der er tale om forskningsresultater, hvor grundlaget er ældre retrospektive data. Det kan oplyses, at der ikke er oplysningspligt om forskningsresultater til tidligere og afsluttede patienter,« skrev Rigshospitalet eksempelvis i en e-mail til Berlingske 26. januar i år.
Den dobbelte kommunikation og især tilbageholdelsen af viden for patienter vækker kritik.
»Jeg kan godt blive lidt bekymret for kulturen omkring patientsikkerheden,« siger professor Søren Birkeland, som forsker i sundhedsret ved Syddansk Universitet.
Han hæfter sig især ved, at man ikke har informeret patienterne om, at årsagen til skimmelinfektionerne er Rigshospitalets egne bygninger.
Samme vurdering kommer fra lektor i sundhedsret ved Aalborg Universitet Kent Kristensen:
»Når der er mistanke om en infektion erhvervet på hospitalet, skal patienter informeres. Også selvom de ikke længere er tilknyttet hospitalet.«
I et skriftligt svar til Berlingske betegner vicedirektør Jannick Brennum fundene af svampesporer som »bekymrende«, men understreger samtidig, at patienter trygt kan lade sig indlægge på Rigshospitalet.
Berlingske har i en måned afdækket store problemer med skimmelsvamp på Rigshospitalet i København.
Kræftramte børn ramt af skimmel
Dækningen har vist, at Danmarks førende hospital har registreret mere end 110 tilfælde af skimmelsvamp i sengestuer, rum og lokaler siden 2018. Senest er det kommet frem, at en række patienter, heriblandt børn i kræftbehandling, er blevet skimmelinficeret direkte fra Rigshospitalets egne bygninger.

Den aktuelle e-mailkorrespondance rokker også ved det indtryk, som Rigshospitalet har efterladt om, hvorfor skimmelinficerede patienter ikke skal orienteres. Nemlig, at der er tale om »ældre retrospektive data«.
Tværtimod har kredsen af skimmelspecialister fra Rigshospitalet og Statens Serum Institut alene det seneste år igen og igen konstateret skimmelsvamp på Rigshospitalet.
Et par eksempler:
I et referat fra et møde blandt forskere og ledende medarbejdere på Rigshospitalet og Statens Serum Institut fra 22. februar 2023 kan man læse følgende:
»Indtil nu er der fundet 9 A. flavus kolonier: 3 på 5053 og 6 på 5054 – men nogle af disse kan være fra 5051«.
A. Flavus refererer til skimmelsvampen Aspergillus flavus, som har plaget Rigshospitalet i flere år. De firecifrede tal er afdelingsnumre. Ifølge referatet er der blandt andet fundet svampe på tre stuer.
Eller som Rigshospitalets klinikchef for Afdeling for Klinisk Mikrobiologi, Jenny Dahl Knudsen, skrev til en gruppe af kolleger 7. marts 2023:
»Den udbrudsstamme af Aspergillus flavus, der har foranlediget 16 tilfælde af infektioner hos patienter, er fundet på de tre afsnit 5051, 5053 og 5054, både i patient rum, skakter og badeværelser,« advarede klinikchefen.
Bekymrende mængder af svampesporer
Det er uvist, hvordan hvert af de 16 smitteforløb har udviklet sig. Afdeling 5054 er ifølge Rigshospitalets egen angivelse afsnittet for »Børn og Unge med Kræft- og Blodsygdomme«. Altså, patienter med nedsat immunforsvar, hvor svampeinfektioner kan være livstruende.
Klinikchefen skrev videre 7. marts 2023, at der var fundet »bekymrende mængder af meget resistente svampe som Aspergillus calidoustus og sydowii på 5053 og 5054«.
I samme e-mail:
»Der er fundet bekymrende mængder af svampesporer i skakter på 5062«.
Og:
»Der er fundet bekymrende mængder og langt over internationale grænseværdier (for ophold af raske personer) af svampesporer i køkkenet på 5053,« advarede Jenny Dahl Knudsen 7. marts 2023.
Klinikchefen er langtfra den eneste, der har været bekymret det forgangne år.
Allerede 16. december 2022 skrev professor og overlæge Maiken Cavling Arendrup til klinikchef Jenny Dahl Knudsen, at der var fundet tre specifikke slags skimmelsvampe og andre skimmelsvampe.
»Du får naturligvis en samlet oversigt, men det er da dybt problematisk og bekymrende,« betonede professoren.

Maiken Cavling Arendrup trådte for nylig frem i et interview med Berlingske og fortalte, hvor alvorligt hun opfatter situationen. De omtalte e-mail understøtter det billede.
3. januar 2023 sendte Maiken Cavling Arendrup endnu en advarsel til udvalgte kolleger:
»Jeg synes, vi har bekymrende fund og samler dem sammen i en præsentation,« skrev professoren.
23. januar 2023 havde man konstateret flere typer svampe. Eksempelvis en specifik skimmelsvamp fra et badeværelse, en anden type skimmelsvamp fra en legestue, et køkken og en stue samt skimmel på yderligere en stue og et badeværelse. Og dette var kun foreløbig, der kunne komme flere til, som professor og overlæge Maiken Cavling Arendrup varslede for en kreds af kolleger.
I mailen 23. januar 2023 advarede hun om, at fundene tegnede et billede af kræftafdelingen for børn som en »skimlet« afdeling, som hun formulerede det, med en såkaldt »husstamme« af arten Aspergillus flavus.
Advarsel på advarsel
Andre e-mail fra det seneste år understøtter billedet af, hvor alvorlig skimmelsagen har været. Her er nogle nedslag:
1. februar 2023 skrev den særlige gruppe med fokus på skimmelsvamp med en centervicedirektør om det videre forløb om at tage skimmelprøver.
20. april 2023 skrev professor Maiken Cavling Arendrup til klinikchef Jenny Dahl Knudsen, at man godt vidste, at der var en kilde til smitten på Rigshospitalet. Forskerne blev således igen i foråret bekræftet i, at patienter blev smittet af Rigshospitalets egne bygninger.
17. maj 2023 var ledelsen igen blevet inddraget. Direktionen blev orienteret om svar fra luftprøver. I samme e-mail omtales nogle af Rigshospitalets lokaler i øvrigt som »svampetunge rum«.
1. september 2023 skrev professor og overlæge Maiken Cavling Arendrup til kredsen af kolleger, at yderligere to voksne patienter var ramt af skimmelsvamp. Det betød, at svampeudbruddet ikke var isoleret til børnekræftafdelingen.
»I min optik er dette uacceptabelt,« fastslog professor Maiken Cavling Arendrup i e-mailen fra 1. september 2023 og skrev videre:
»Og hvis der ikke er penge til at renovere, spørger jeg mig selv, om beslutningstagere/politikere er klar over denne situation.«
Spørgsmålet om erstatning
Samme dag skrev Maiken Cavling Arendrup i en anden e-mail til samme kolleger:
»De patienter er vel også berettiget til erstatning.«
Ifølge Berlingskes oplysninger var spørgsmålet om erstatning også tidligere blevet rejst i den kreds af ansatte, som har håndteret udbruddet af især skimmelsvampen Aspergillus flavus.

4. september 2023 skrev klinikchef Jenny Dahl Knudsen, at de var nødt til at bringe emnet om skimmelsvamp op på direktionsniveau.
Klinikchef Jenny Dahl Knudsen uddyber over for Berlingske, at man på grund af »den mulige ophobning« af patienter smittet med typen Aspergillus flavus foretog en undersøgelse af luften og fandt kilden til svampeinfektionerne i Rigshospitalets egne bygninger.
Hun understreger, at Rigshospitalet har reageret over for alle tilfælde af skimmelsvamp og undersøgt kilden.

Klinikchefen understreger dog også alvoren i, at indlagte patienter har pådraget sig skimmel.
»Det er da højst uheldigt. Der er intet godt at sige om det. Det er aldrig godt at få en infektion oven i en alvorlig sygdom,« siger Jenny Dahl Knudsen.
Over for Berlingske uddyber professor Maiken Cavling Arendrup, at hendes bekymring i de omtalte e-mail skyldes, at der »måtte være en fælles kilde til disse infektioner på Rigshospitalet og dermed en fortsat risiko for ny smitte«.
Hun oplevede, at Rigshospitalet lyttede til hendes bekymring, og oplyser, at der er tale om et helt usædvanligt svampeudbrud på hospitalet.
En stråmand
Maiken Cavling Arendrup understreger, at hun ikke er ekspert i patienterstatning, men forklarer sit input om mulig erstatning i den omtalte e-mail således:
»Da spørgsmålet om patienterstatning tidligere havde været rejst i forhold til udbrudshåndteringen på afdelingen for børn og unge, var det vigtigt for mig at sikre, at de behandlende læger på voksenafdelingen var orienteret om, at disse patienter også var en del af det samme udbrud, som andre patienter havde erhvervet sig fra hospitalet.«
Sagen opsummeret:
Udadtil har Rigshospitalet således den seneste måned oplyst patienter og medier om, at skimmelsvampen var under kontrol, og at der ikke var grund til bekymring. Men e-mail viser, at man bliver ved med at finde helt nye udbrud, og at de ansatte er dybt bekymrede.
Udadtil fastholder Rigshospitalet, at man ikke bør orientere patienter om, at de er blevet skimmelinficeret fra Rigshospitalets bygninger. Men internt har de sågar talt om erstatningsmulighed for de berørte patienter.
Lektor i sundhedsret Kent Kristensen er kritisk over for Rigshospitalets håndtering.
»Det er en stråmand, at forskningsdata skulle betyde, at patienter ikke skal informeres,« siger han.
Kent Kristensen hæfter sig også ved, at Rigshospitalets ledelse er blevet informeret undervejs, ligesom han betoner, at de skimmelramte patienter reelt er blevet afskåret fra at søge erstatning, når de intet har fået at vide om, at Rigshospitalet selv er kommet til at smitte patienterne.
»Informationspligten er sat i verden for, at patienterne skal undgå et retstab, og derfor har Rigshospitalet pligt til at informere patienter i disse sager,« siger Kent Kristensen.
Professor i sundhedsret Søren Birkeland når frem til samme konklusion:
»Jeg synes, at det fremgår meget klart af lovgivningen, at når man har informationer, som peger på, at der er indtrådt skader under sygehusbehandling, som må antages at kunne give ret til erstatning, så skal man informere patienten om det,« siger professoren.
Rigshospitalet: Vi har taget det alvorligt
Vicedirektør ved Rigshospitalet Jannick Brennum har sendt Berlingske et længere skriftligt svar. Om forskellen på, hvad Rigshospitalet har oplyst offentligt og indholdet i de omtalte e-mail, understreger vicedirektøren, at Rigshospitalet hele tiden har »taget situationen alvorligt«.
»På Rigshospitalet gør vi alt, hvad vi kan, for at mindske risiko for infektioner med alle former for svampesporer, herunder også skimmelsvampe, og vi overvåger området nøje for netop at kunne sætte ind hurtigt ved behov,« skriver Jannick Brennum.
Han holder dog fast i Rigshospitalets linje om at berolige fremtidige patienter.
»Patienter kan fortsat trygt lade sig indlægge på Rigshospitalet i vished om, at vi hver dag gør alt, hvad vi kan, for at give vores patienter den bedste og mest omsorgsfulde behandling og pleje,« skriver vicedirektøren.
Han oplyser dog, at en undersøgelse i 2022-2023 viste, at flere prøver indeholdt præcis den samme skimmelsvamp, hvorfor der blev foretaget »en række miljøundersøgelser«.
Undersøgelserne »påviste bekymrende mængder af svampesporer, hvorfor der blev iværksat forsegling af skakter, renovering og rengøring,« skriver Jannick Brennum.
»Forekomsten af svampesporer i miljøet var således bekymrende og krævede handling. Det er imidlertid ikke det samme, som at patienterne skal være bekymrede for at modtage behandling på Rigshospitalet,« understreger vicedirektøren.





